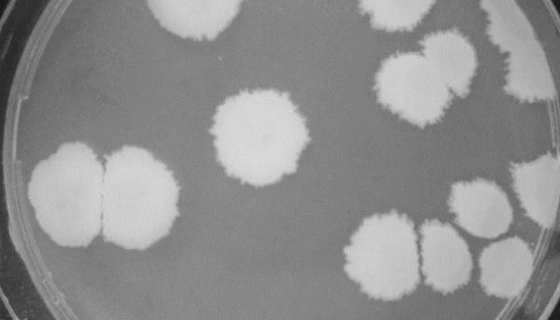
地衣形芽孢杆菌的菌株培养与注意事项及保存方法！
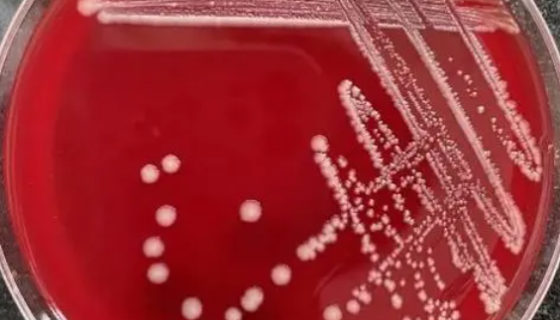
ATCC 25296 胺胨罗斯氏菌的培养及打管说明！

ATCC 43185 粪拟杆菌的特点与优势及其培养!
拟杆菌属(Bacteroides)是指革兰氏染色阴性、无芽孢...
地衣形芽孢杆菌的菌株培养与注意事项及保存方法!
地衣芽孢杆菌(学名:Bacillus licheniform...

人T淋巴母细胞瘤细胞复苏与传代及冻存实验步骤!
人T淋巴母细胞瘤细胞的复苏与传代及冻存实验步骤与操作说明!
ATCC 25296 胺胨罗斯氏菌的培养及打管说明!
ATCC 25296胺胨罗斯氏菌的特点与优势及培养方法!

棒曲霉的形态描述与培养方法及注意事项!
棒曲霉是杯霉科真菌。菌落呈茸毛状,略带皱纹,灰绿色。分生孢子...

人脑胶质细胞株收到后处理方法与培养步骤!
人脑胶质细胞株仅用于科学研究或者工业应用等非医疗目的不可用于...

人牙周膜成纤维细胞的性质用途与生产工艺!
人牙周膜成纤维细胞分离自牙周膜组织。刚分离的人牙周膜成纤维细...

扩展青霉——用于研究和生产及微生物转化
扩展青霉,菌落蓝绿色,绒状,背面鲜黄色至带橙红色,小梗密集,...

MN9D小鼠中脑多巴胺能神经元细胞的应用!
MN9D小鼠中脑多巴胺能神经元细胞来源于一位72岁的男性结直...